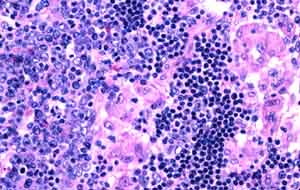
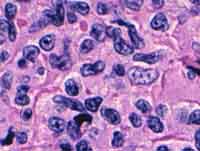

Go to:

TOC
|
Toxoplasmosis in Lymph Nodes
 At the lower left and right are hyperplastic follicles with aggregates of epithelioid histiocytes encroaching on them from the middle. On the upper right are hyperplastic monocytoid B-cells. The follicles, histiocytes, and monocytoid B-cells compose the classic triad. |
A higher power view of the hyperplastic follicle on the left and the histiocytes encroaching from the right. |
The famous monocytoid B-cells. Note the small, reniform nuclei, modest amounts of cytoplasm, and distinct cell borders. |
Table of Contents
|